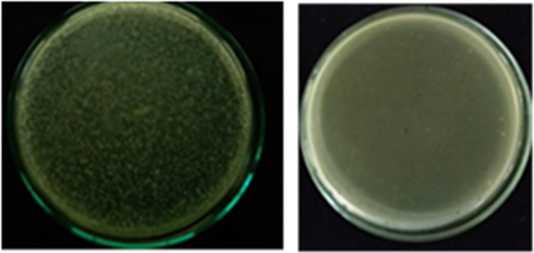
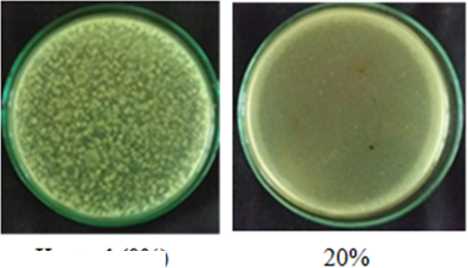
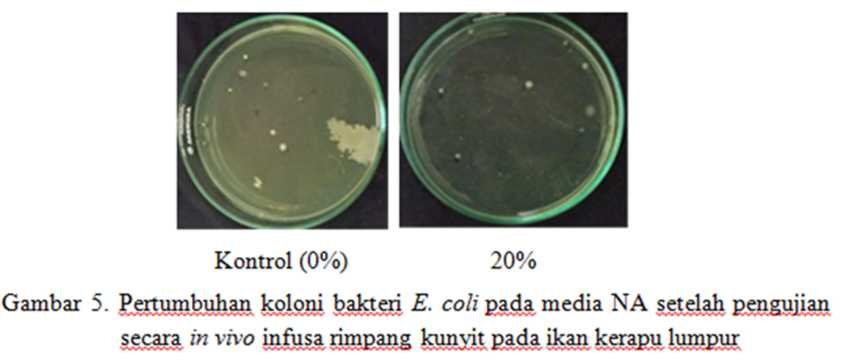

DAYA HAMBAT INFUSA RIMPANG KUNYIT (Curcuma longa Linn) TERHADAP PERTUMBUHAN Escherichia coli dan Vibrio sp. pada IKAN KERAPU LUMPUR (Epinephelus tauvina) di PASAR KEDONGANAN KABUPATEN BADUNG, BALI
on
JURNAL SIMBIOSIS V (2 ): 52 - 57
Jurusan Biologi FMIPA Universitas Udayana http://ojs.unud.ac.id/index.php/simbiosis
ISSN: 2337-7224
September 2017
Directoryof OPEN ACCESS JOURNALS
DAYA HAMBAT INFUSA RIMPANG KUNYIT (Curcuma longa Linn) TERHADAP PERTUMBUHAN Escherichia coli dan Vibrio sp. pada IKAN KERAPU LUMPUR (Epinephelus tauvina) di PASAR KEDONGANAN KABUPATEN BADUNG, BALI
THE POWER OF INHIBITION TURMERIC INFUSA RHIZOME (Curcuma longa Linn) TO GROWTH Escherichia coli AND Vibrio sp. IN MUDFISH GROUPHER (Epinephelus tauvina) ON THE KEDONGANAN MARKET KABUPATEN BADUNG, BALI
Ni Putu Sinta Puspa Dewi, I. B. Gede Darmayasa, Ni Wayan Sudatri
*
Program Studi Biologi, Fakultas MIPA, Universitas Udayana, Bali
*
Email : puspadewisinta@gmail.com
INTISARI
Ikan merupakan bahan pangan yang mengandung protein dan air yang cukup tinggi, sehingga mudahrusak oleh mikroorganisme. Oleh karena itu pengendalian mikroorganisme perlu dilakukan untuk mempertahankan kualitas ikan agar tetap terjaga. Kunyit adalah salah satu bahan herbal yang memiliki kandungan senyawacurcumin dan fenolik yang mampu mengendalikan pertumbuhan mikroorganisme kontaminan. Penelitian ini bertujuan untuk mengetahui daya hambat infusa rimpang kunyit (Curcuma longa Linn) melalui perendaman ikan kerapu lumpur (Epinephelus tauvina)yang diambildari pasar Kedonganan, Bali. Perlakuan yang diberikan adalah infusa rimpang kunyit dengan konsentrasi 0%, 5%, 10%, 15% dan 20% yang diujikan secara in vitro dan in vivo terhadap pertumbuhan E. coli dan Vibrio sp. Pengamatan daya hambat infusa rimpang kunyit ditentukan dengan menghitung populasi bakteri uji setelah perlakuan dengan metode pengenceran (Plating Method). Hasil penelitian menunjukkan bahwa infusa rimpang kunyit secara signifikan (P<0,05) mampu menghambat pertumbuhan E. coli dan Vibrio sp. baik secara in vitro maupun in vivo.Pada Kontrol (0%) secara invitro populasi E. coli dan Vibrio sp.masing-masing sebesar 5,23x102 CFU/gdan4,98x102 CFU/glebih tinggi dibandingkan dengan perlakuan konsentrasi 5%, 10%, 15% dan 20%.Populasi E. coli dan Vibrio sp. pada pengujian secara in vivo (konsentrasi 0%) masing-masing diperoleh 4,17x102 CFU/g dan 4,20x102 CFU/g secara statistik berbeda nyata (P<0,05) dengan perlakuan konsentrasi 10%, 15% dan 20%.
Kata Kunci : Epinephelus tauvina, Curcuma longa Linn, E. coli, Vibrio sp.
ABSTRACT
Fish is perishable food because it contains high enough protein and water, therefore to easy damaged by microorganism. Then the control of mircoorganism should be done to maintaining the quality of fish to stay awake.Turmeric is one of the herbs that has compound content curcumin and fenolik being able to control the growth of contaminants microorganism. The objective of this research is to find out the power of immersion of mudfish grouper (Epinephelus tauvina) by infusa turmeric rhizome (Curcuma longa Linn) through sampled from Kedonganan Market, Bali. The treatment given to mudfish grouper was turmeric rhizome infusion with concentration of 0%, 5%, 10%, 15% and 20% tested in vitro and in vivo on the growth of E. coli and Vibrio sp. The resources inhibited turmeric infusa rhizome is determined by counting the population of bacteria test after treatment by the method of dilution sampling (Plating Method). The results showed that turmeric rhizome infusion was able significantly (P<0,05) inhibitionto the growth of E. coli and Vibrio sp. both in vitro and in vivo. The control (0%) in vitro population E. coli and Vibrio sp. each of 5,23x102 CFU/g and 4,98x102 CFU/g higher than with the treatment of concentration 5%, 10%, 15% and 20%. Population E. coli and Vibrio sp. in testing by in vivo (concentration 0%) each is obtained 4,17x102 CFU/g dan 4,20x102 CFU/g in statistic is different (P<0,05) with the concentration 10%, 15% and 20%.
Keywords: Epinephelus tauvina, Curcuma longa Linn, E. coli, Vibrio sp.
PENDAHULUAN
Ikan adalah bahan pangan yang mudah mengalami pembusukan oleh mikroba karena mengandung kadar air dan protein yang cukup tinggi. Secara alami ikan umumnya diawetkan dengan beberapa cara yaitu penggaraman, pengeringan dan penambahan es batu. Cara ini banyak dilakukan karena relatif murah dan mudah dilakukan oleh masyarakat. Teknik penggaraman ikan membuat ikan menjadi awet tetapi jika berlebihan akan mempengaruhi rasa pada daging ikan juga akan menyebabkan penyakit. Sedangkan penambahan es batu berperan dalam mengawetkan ikan, tetapi dengan perantara air mikroba pembusuk akan mudah masuk ke dalam ikan sehingga menyebabkan ikan mudah terkontaminasi. Beberapa jenis bakteri yang menyebabkan bahan pangan berbahan dasar ikan mudah rusak diantaranya;bakteri Salmonella sp., Pseudumonas sp., Vibrio sp., Bacillus sp. dan Escherichia coli (Dharmawati dan Dewi, 2008).
Escherichia coli merupakan bakteri flora normal yang hidup di dalam usus manusia dan hewan mamalia. Pada kondisi
tertentu dapat menjadi patogen seperti apabila berada diorgan lain diluar saluran pencernaan yang dapat menyebabkan peradangan. Hal ini terjadi jika kekebalan tubuh lemah pada daerah tersebut. Sedangkan Vibrio sp. merupakan bakteri patogen yang menginfeksi dan menyebabkan penyakit saat kondisi kekebalan tubuh lemah (Felix dkk., 2011).
Ikan kerapu lumpur(Epinephelus tauvina) merupakan salah satu jenis ikan yang banyak dikonsumsi oleh masyarakat. Untuk menjaga kualitas ikan pasca penangkapan tetap stabil maka sangat perlu dilakukan pengawetan yang murah dan tanpa menimbulkan efek samping yang berbahaya bagi manusia yang mengkonsumsinya. Pengawet yang paling baik adalah menggunakan bahan pengawet alami yang bersumber dari bagian tumbuhan-tumbuhan.Kunyit merupakan salah satu obat bahan tradisional Indonesia yang memiliki kandungan senyawa curcumin. Selain itu,kunyit juga memiliki senyawa khusus antibakteri yang berkemampuan menghambat
Directoryof OPEN ACCESS JOURNALS
pertumbuhan bakteri patogen yaituSalmonella sp. dan E. coli(Syaputri dkk., 2010).
Menurut penelitian Pangemanan dkk. (2016),hasil pengujian daya hambat ekstrak polar rimpang kunyit (Curcuma longa) terhadap aktivitas pertumbuhan Staphylococcus aureus memiliki nilai positif. Rata-rata diameter zona hambat pada ekstrak 5%, 10%, 20% dan 40% secara berurutan yaitu 11,0 mm, 13,5 mm, 14,5 mm, dan 15,0 mm dan pengujian daya hambat ekstrak polar rimpang kunyit (Curcuma longa) terhadap aktivitas pertumbuhan bakteri Pseudomonas sp. memiliki nilai positif. Rata-rata diameter zona hambat pada ekstrak 5%, 10%, 20% dan 40% secara berurutan yaitu 8,8 mm, 9,3 mm, 11,1 mm, dan 13,1 mm. Berdasarkan hal inilah perlu dilakukan penelitian tentang daya hambat infusa rimpang kunyit terhadap pertumbuhan bakteri E. coli dan Vibrio sp. secara in vitro dan in vivo pada ikan kerapu lumpur.
METODE PENELITIAN
Penyiapan Infusa Rimpang Kunyit
Penyiapan infusa rimpang kunyit yaitu dengan memotong rimpang kunyit hingga menjadi ukuran kecil, kemudian dihancurkan menggunakan blender lalu dikering anginkan. Setelah itu ditambahkan aquades sebanyak 200 mL hingga diperoleh konsentrasi 5%, begitu juga seterusnya untuk perlakuan 10%, 15% dan 20% lalu dipanaskan hingga 90oC. Setelah itu disaring infusa untuk memisahkan simplisia menggunakan kertas saring.
Pembuatan Suspensi Bakteri Uji (Escherichia coli dan Vibrio sp.)
Suspensi bakteri uji yaitu dengan menyiapkan media NB (Nutrient Broth) dan stok kultur bakteri uji (E. coli dan Vibrio sp.). Sebelum digunakan untuk pengujian, bakteri uji tersebut ditumbuhkan pada media EMBA (E. coli) dan media TCBS (Vibrio sp.). Pembuatan suspensi bakteri uji dengan diambil 1 loop pada koloni bakteri uji kemudian dimasukkan ke dalam erlenmeyer yang telah berisi media NB lalu diinkubasi selama 24 jam pada suhu 370C, bakteri yang telah tumbuh siap digunakan sebagai bakteri uji.
Uji Daya Hambat Infusa Rimpang Kunyit Terhadap Escherichia coli dan Vibrio sp. Secara in Vitro
Suspensi bakteri uji (E. coli dan Vibrio sp.) diambil sebanyak 200 µL lalu dimasukkan ke dalam cawan Petri steril kemudian ditambahkan 1 mL infusa rimpang kunyit dengan masing – masing konsentrasi 5%, 10%, 15% dan 20%. Sedangkan konsentrasi 0% (kontrol) ditambahkan air steril. Selanjutnya semua perlakuan dituangkan media NA (Nutrient Agar) (± 400C) sebanyak 15 mL ke masing – masing cawan Petri lalu diinkubasi pada suhu 370C selama 24 jam. Semua perlakuan diulang sebanyak 4 kali dan daya hambat infusa rimpang kunyit dapat dilihat dengan menghitung jumlah koloni pada masing – masing perlakuan.
Uji in Vivo Daya Hambat Infusa Rimpang Kunyit (Curcuma longa Linn) Terhadap E. coli dan Vibrio sp. pada Ikan Kerapu Lumpur
Teknik pengambilan Sampel
Sampel ikan diambil di Pasar Kedonganan Kab. Badung, Bali secara acak dengan cara diambil pada pedagang
yang didekat pintu masuk, pintu keluar, bagian tengah, bagian ujung dan di dekat kamar mandi. Sampel ikan yang diambil sebanyak 25 ekor dan dipilih sesuai dengan berat rata – rata12 kg. Kemudian sampel ikan dimasukkan ke kantong plastik steril lalu diletakkan dalam cool box. Setelah itu dibawa ke Laboratorium Mikrobiologi Universitas Udayana untuk dilakukan pengujian.
Uji in Vivo Daya Hambat Infusa Rimpang Kunyit (Curcuma longa Linn) Terhadap E. coli dan Vibrio sp. pada Ikan Kerapu Lumpur
Sampel ikan kerapu yang diambil di pasar Kedonganan dengan berat rata – rata 12 kg dibilas dengan air steril lalu diberi perlakuan. Empat ekor ikan kerapu yang telah disiapkan lalu masing-masing diswab sebanyak 15 ml suspensi bakteri uji (E. coli dan Vibrio sp.) kemudian didiamkan 30 menit. Selanjutnya dilakukan perendaman dengan infusa rimpang kunyit konsentrasi 5% selama 2 jam. Perlakuan yang sama untuk empat ekor ikan kerapu lumpur berikutnya, hanya saja konsentrasi perendaman infusa rimpang kunyit 10%, begitu seterusnya untuk konsentrasi 15% dan 20%. Sedangkan kontrol (0%) direndam dengan air steril. Setelah perendaman selama 2 jam, ikan diambil bagian daging dan diletakkan dalam wadah untuk dianalisis reduksi jumlah E. coli dan Vibrio sp.
Penentuan Jumlah Total E. coli dan Vibrio sp. pada Perlakuan
Total E. coli dan Vibrio sp. pada sampel ikan kerapu lumpur yang sudah diberi perlakuan dilakukan dengan menimbang 10 gram sampel dagingnya kemudian dimasukkan kedalam botol steril yang berisi 90 mL air steril (pengencer 101). Untuk pengenceran 10-2 dilakukan dengan cara mengambil 1 mL pengenceran 10-1 lalu dimasukkan ke dalam tabung reaksi yang berisi 9 mL air steril. Cara yang sama juga dilakukan untuk pengenceran 10-3, lalu masing–masing pengenceran diambil 1 mL dan dimasukkan ke cawan Petri steril. Selanjutnya dituangkan media Nutrien Agar (400C) lalu digoyang secara simultan lalu diinkubasi pada suhu 370C selama 24 jam (Fardiaz, 1993). Kemudian dilakukan perhitungan jumlah bakteri.
HASIL
Hasil uji bakteri Escherichia coli dan Vibrio sp. yang diperoleh dari BPOM Denpasar menunjukkan bahwa bakteri E. coli yang ditumbuhkan pada media EMBA menampilkan koloni berwarna hijau metalik, sedangkan Vibrio sp. yang ditumbuhkan pada media TCBS menampilkan koloni berwarna hijau. Pengamatan mikroskopis sel bakteri E. coli berbentuk batang dengan hasil pewarnaan Gram menampilkan warna dinding sel berwarna merah yang termasuk bakteri Gram negatif (Gambar 1), Sedangkan bakteri Vibrio sp. yang berbentuk batang bengkok dengan hasil pewarnaan Gram menampilkan warna dinding sel berwarna merah termasuk dalam bakteri Gram negatif (Gambar 2).
DIRECTORY OF
OPEN ACCESS
JOURNALS

Ket : (1) Bakteri E. coli
Gambar 1. Koloni E. coli yang ditumbuhkan pada media EMBA (A) dan gambar mikroskopis E. coli perbesaran IOOx (B)

Ket : (1) Bakteri Vibrio sp.
Gambar 2. Koloni Vibrio sp. yang ditumbuhkan pada media TCBS (A) dan gambar mikroskopis Vibrio sp. perbesaran IOOx (B)
Uji in Vitro Daya Hambat Infusa Rimpang Kunyit (Curcuma longa Linn) Terhadap E. coli dan Vibrio sp.
Pengujian secara in vitro daya hambat infusa rimpang kunyit terhadap bakteri E. coli menunjukkan bahwa infusa
tersebut mampu menghambat pertumbuhan bakteri E. coli 2
dengan rata – rata sebesar5,23x102CFU/g, jauh lebih besar jika dibandingkan dengan pemberian infusa rimpang kunyit pada konsentrasi 20% rata – rata jumlah E. coli sebesar 3,87x102CFU/g.
Tabel 1. Rata-rata jumlah E. coliyang tumbuh pada media pertumbuhan yang diberi beberapa konsentrasi infusa rimpang kunyit
No. |
Perlakuan (%) |
Jumlah E. Coli (102)(CFU/g) |
1 |
0 |
5,2333± 0,380c |
2 |
5 |
4,6133± 0,015b |
3 |
10 |
4,7167±0,087b |
4 |
15 |
4,6633±0,097b |
5 |
20 |
3,8767±0,065a |
Ket. Notasi huruf yang sama dibelakang nilai rata-rata pada kolom yang sama menunjukkan jumlah E. coli yang tidak berbeda nyata pada uji statistik Anova dan Duncan (P>0,05)
Demikian juga pada pemberian konsentrasi infusa rimpang kunyit pada konsentrasi 5%, 10%, 15% berturut – turut adalah 4,61x102 CFU/g, 4,71x102CFU/g dan
4,66x102CFU/g(Tabel 1). Pertumbuhan bakteri E.coli di media NA pada perlakuan kontrol (0%) dan konsentrasi 20% dapat dilihat pada Gambar 3.
Kontrol (0%) 20%
Gambar 3. Pertumbuhan koloni bakteri E. coli pada media NA yang diberikan konsentrasi infusa rimpang kunyit (secara in vitro)
DIRECTORY OF
OPEN ACCESS
JOURNALS
Hal yang sama juga terjadi pada pengujian daya hambat infusa rimpang kunyit terhadap bakteri Vibrio sp. pada Tabel 2. rata – rata jumlah bakteri Vibrio sp. pada kontrol (0%) sebesar 4,98x102CFU/g jauh lebih besar jika dibandingkan dengan perlakuan infusa rimpang kunyit pada konsentrasi 20% (Tabel
2). Demikian juga tampak terjadi penurunan jumlah Vibrio sp. pada perlakuan yang diberikan infusa rimpang kunyit pada konsentrasi 5%, 10% dan 15% jika dibandingkan dengan kontrol yang hanya diberikan air steril (Gambar 4).
Tabel 2. Rata-rata jumlah Vibrio sp.yang tumbuh pada media pertumbuhan yang diberi beberapa konsentrasi infusa rimpang kunyit
No. |
Perlakuan (%) |
Jumlah Vibrio sp. (102) (CFU/g) |
1 |
0 |
4,9867 ± 0,020d |
2 |
5 |
4,7233 ± 0,032b |
3 |
10 |
4,8467± 0,040c |
4 |
15 |
4,6900± 0,036b |
5 |
20 |
4,2933± 0,125a |
Ket. Notasi huruf yang sama dibelakang nilai rata-rata pada kolom yang sama menunjukkan jumlah bakteri yang tidak berbeda nyata pada uji statistik Anova dan Duncan (P>0,05)
Kontrol (0%)
Gambar 4. Pertumbuhan koloni bakteri Vibrio sp. pada media NA yang diberikan konsentrasi infusa rimpang kunyit (secara in vitro)
Uji in Vivo Daya Hambat Infusa Rimpang Kunyit dengan Perendaman Ikan Kerapu Lumpur Terhadap E. coli dan Vibrio sp.
Hasil pengujian daya hambat infusa rimpang kunyit terhadap E. coli dan Vibrio sp. secara in vivomenunjukkan rata-rata jumlah bakteri E. coli pada ikan kerapu yang diberikan perendaman infusa rimpang kunyit pada konsentrasi 20%
sebesar 3,70x102CFU/g jauh lebih rendah jika dibandingkan dengan kontrol (0%) yang diberikan perendaman dengan air yaitu sebesar 4,17x102CFU/g. Demikian pula pada konsentrasi 5%, 10% dan 10% secara berturut – turut jumlah total sebesar 4,11x102CFU/g, 3,97x102CFU/g dan 3,87x102CFU/g yang juga lebih rendah dibandingkan dengan perlakuan kontrol (0%), data selengkapnya dapat disajikan pada Tabel 3 dan Gambar 5.
Tabel 3. Rata-rata jumlah E. colipada ikan kerapu lumpur yang diberi perendaman beberapa konsentrasi infusa rimpang kunyit selama 2 jam
No. |
Perlakuan (%) |
Jumlah E. Coli(102) (CFU/g) |
1 |
0 |
4,1700 ± 0,0244d |
2 |
5 |
4,1150± 0,0331d |
3 |
10 |
3,9750± 0,0288c |
4 |
15 |
3,8700 ± 0,0346b |
5 |
20 |
3,7075± 0,0809a |
Ket. Notasi huruf yang sama dibelakang nilai rata-rata pada kolom yang sama menunjukkan jumlah bakteri yang tidak berbeda nyata pada uji statistik Anova dan Duncan (P>0,05)
Gambar
Kontrol (0%)
20%
5 Penumbuhan koloni bakteri E. coh pada media NA setelah pengujian secara in vivo infusa rimpang kunyit pada ikan kerapu lumpur
55
DIRECTORY OF
OPEN ACCESS
JOURNALS
Hal yang sama juga terjadi pada jumlah bakteri Vibrio sp. pada perlakuan infusa rimpang kunyit dengan konsentrasi 20% jumlah bakteri sebesar 3,85x102CFU/g lebih rendah dibandingkan dengan perlakuan kontrol (0%) sebesar
4,20x102CFU/g. Demikian pula pada konsentrasi 5%, 10% dan 15% berturut – turut sebesar 4,15x102CFU/g, 3,89x102CFU/g dan 3,97x102CFU/g data selengkapnya disajikan pada Tabel 4 dan Gambar 6.
Tabel 4. Rata-rata jumlah bakteri Vibrio sp. pada ikan kerapu lumpur yang diberi perendaman beberapa konsentrasi infusa rimpang kunyit selama 2 jam
No. |
Perlakuan (%) |
Jumlah Vibrio sp (102) (CFU/g) |
1 |
0 |
4,2050± 0,0412c |
2 |
5 |
4,1550± 0,0387c |
3 |
10 |
3,8975± 0,0450b |
4 |
15 |
3,9725± 0,0607b |
5 |
20 |
3,8525± 0,0618a |
Ket. Notasi huruf yang sama dibelakang nilai rata-rata pada kolom yang sama menunjukkan jumlah bakteri yang tidak berbeda nyata pada uji statistik Anova dan Duncan (P>0,05)

Kontrol (0%) 20%
Gambar 6. Pertumbuhan koloni bakteri Vibrio sp. pada media Agar setelah pengujian secara in vivo infusa rimpang kunyit pada ikan kerapu lumpur
PEMBAHASAN
Infusa rimpang kunyit yang diujikan secara in vitro ternyata mampu menghambat pertumbuhan bakteri yang diujikan. Hasil analisis statistik menunjukkan bahwa secara signifikan (P<0,05) infusa rimpang kunyit mampu menghambat pertumbuhan bakteri E. coli. Rata – rataE.coli 2
pada kontrol (0%) sebesar5,23x102CFU/g jauh lebih besar jika dibandingkan dengan pemberian infusa rimpang kunyit pada konsentrasi 20% sebesar 3,826x102CFU/g. Jika dilihat beda rata-rata antara perlakuan kontrol (0%) dengan konsentrasi 5%, 10%, 15% dan 20% terdapat perbedaan yang sangat nyata (P<0,05), tetapi antara perlakuan konsentrasi 5%, 10% dan 15% tidak terdapat perbedaan nyata (P>0,05). Demikian juga pada pengujian daya hambat infusa rimpang kunyit terhadap pertumbuhan Vibrio sp. secara in vitro juga memberikan hasil yang positif. Hal ini berarti infusa tersebut juga mampu menghambat pertumbuhan Vibrio sp. Rata – rata jumlah bakteri Vibrio sp. pada kontrol (0%) sebesar 4,98x102CFU/g jauh lebih besar jika dibandingkan dengan perlakuan infusa rimpang kunyit pada konsentrasi 20% sebesar 4,29x102. Sedangkan pada konsentrasi 5%, 10% dan 15% berturut-turut jumlah vibrio sp. yang hitung adalah 4,72 x102 CFU/g, 4,8467 CFU/g dan 4,69 CFU/g. Hasil uji beda rata-rata antar perlakuan menunjukkan bahwa hampir semua perlakuan berbeda nyata (P<0,05) kecuali antara perlakuan konsentrasi 5% dan 15%. Ada perbedaan jumlah bakteri uji setelah diberikan perlakuan secara in vitro membuktikan bahwa faktor konsentrasi sangat berpengaruh terhadap kemampuan infusa kunyit dalam menghambat pertumbuhan bakteri uji (E. coli dan Vibrio sp.).
Secara umum semakin besar konsentrasi yang diberikan maka semakin sedikit jumlah bakteri uji yang terhitung dalam cawan Petri.
Adanya kemampuan daya hambat infusa rimpang kunyit terhadap pertumbuhan kedua bakteri yang diujikan (E. coli dan Vibrio sp.) secara in vitro, membuktikan bahwa ada senyawa yang berfungsi sebagai bekteriostatik yang terkandung dalam infusa yang berperan menghambat pertumbuhan bakteri yang diujikan. Hal ini dipertegas dengan pendapat Jamilah dkk. (2015) bahwa kunyit memiliki kandungan minyak atsiri dan curcumin terbukti mampu membunuh bakteri yang bersifat bakterisidal. Pendapat yang sama dikatakan oleh Maharni dkk. (2014) bahwa kunyit memiliki senyawa curcumindan senyawa fenolik, yang berfungsi sebagai antimikroba.Fenol mempunyai sifat bakteriostatik dan bakterisidal, biasanya digunakan sebagai desinfektan. Senyawa fenol berperan sebagai antimikroba,bekerja dengan cara mendenaturasi protein dan merusak membran sel. Selain itu senyawa antibakteri bereaksi dengan dinding sel pada bakteri yang menyebabkan permeabilitas pada sel bakteri menyusut kemudian berdifusi ke dalam sel yang mengakibatkan pertumbuhan bakteri terhambat (bakteriostatik) atau mati (bakterisidal). Senyawa antibakteri ini juga mampu bereaksi dengan komponen genetik dan menembus membran pada sel sehingga mengalami mutasi (Roihanah dkk., 2012).
Pengujian infusa rimpang kunyit secara in vivo melalui perendaman ikan kerapu lumpur selama 2 jam menunjukkan secara konsisten infusa tersebut mampu menghambat pertumbuhan bakteri E. coli maupun Vibrio sp.Lamanya
ΓΛΓ> Λ I Directoryof OPEN ACCESS
L√kJΛΛ⅛J JOURNALS
perendaman mempengaruhi daya hambat terhadap bakteri karena semakin lama perendaman ikan maka semakin tinggi kualitas ikan tersebut karena kandungan pada kunyit yang bersifat bakterisidal dan bakteristatik (Paulus, 2015).
Menurut Jamilah dkk., (2015) daya hambat infusa rimpang kunyit terhadap E. coli lebih tinggi dibandingkan Vibrio sp. Hal ini mengindikasikan bahwa bakteri E. coli lebih rentan dibandingkan Vibrio sp.karena bakteri E. coli merupakan bakteri non patogen penyebab penyakit.E. coli merupakan bakteri normal pada usus danmemiliki struktur dinding sel berupa lapisan peptidoglikan yang tipis sehingga mudah ditembus oleh senyawa antibakteri, sedangkan bakteri Vibrio sp. sebaliknya. Hal ini didukung oleh pendapat Trianto dkk. (2004) bahwa bakteri Vibriosp. merupakan bakteri Gram negatif yang memiliki lapisan peptidoglikan yang dapat menentukan bentuk sel serta memberikan kekakuan untuk melindungi bakteri dari permeabilitas sel yang disebabkan oleh senyawa antibakteri seperti curcuminsehingga Vibrio sp. tingkat sensitivitasnya lebih rendah terhadap senyawa antibakteri curcumin
SIMPULAN
Hasil penelitian menunjukkan bahwa infusa rimpang kunyit mampu menghambat pertumbuhan bakteri Escherichia coli dan Vibrio sp. secara nyata (P<0,05) pada ikan kerapu lumpur (Epinephelus tauvina) yang dilihat dari total bakteri baik secara in vitro maupun in vivo.
SARAN
Perlu dilakukan penelitian lebih lanjut mengenai penambahan konsentrasi infusa rimpang kunyit yang paling optimal dalam perendaman ikan kerapu lumpur, atau menggunakan jenis rimpang yang lain dalam meningkatkan mutu kualitas ikan.
UCAPAN TERIMAKASIH
Penulis mengucapkan terimakasih kepada Dr. Dra. Retno Kawuri, M.Phill. atas peminjaman laboratorium selama penelitian. Serta kepada Dr. I Ketut Ginantra, S.Pd., M.Si. selaku Ketua Program Studi Biologi FMIPA Universitas Udayana yang telah memberikan fasilitas dalam menulis jurnal dan skripsi.
DAFTAR PUSTAKA
Dharmawati, S. dan Dewi, S. S. 2008. Efek Ekstrak Buah Pare (Momordi charantia L.) Terhadap Zone Hambatan Pertumbuhan Salmonella typhi Penyebab Salmonellosis. Jurnal Kesehatan. 1(1).
Fardiaz, S. 1993. Analisis Mikrobiologi Pangan. Liberty. Yogyakarta.
Felix, Feliatra., Titania T. Nugroho., Sila Silalahi dan Yuslina Octavia. 2011. Skrining Bakteri Vibrio sp. Asli Indonesia Sebagai Penyebab Penyakit UdangBerbasis Tehnik 16S Ribosomal DNA. Jurnal Ilmu dan Teknologi Kelautan Tropis. 3(2) : 85-99.
Jamilah, L., Agustina dan S. Purwati. 2015. Daya Hambat Antibakteri Pakan dengan Kombinasi Kunyit, Bawang Putih dan Zink Terhadap Staphylococcus Aureus dan
Escherichia coli. Jurnal Buletin Nutrisi dan Makanan Ternak. 11(1) : 7–13.
Maharni., Fitrya., Milanti Oktaruliza dan Elfita. 2014. Uji Aktivitas Antibakteri dan Antioksidan Senyawa Derivat Piranon dari Mikroba Endofitik Penicillium sp. pada Tumbuhan Kunyit Putih (Curcuma zedoaria (Berg.) Roscoe). Traditional Medicine Journal. 19(3) : 107-112.
Pangemanan, A., Fatimawali dan Fona Budiarso. 2016. Uji daya hambat ekstrak rimpang kunyit (Curcuma longa) terhadap pertumbuhan bakteri Staphylococcus aureus dan Pseudomonas sp. Jurnal e-Biomedik. Fakultas
Kedokteran Universitas Sam Ratulangi Manado. 4(1).
Paulus, Carolus Paruntu. 2015. Budidaya Ikan Kerapu (Epinephelus tauvina Forsskal, 1977) dan Ikan Baronang (Siganus canaliculatus Park, 1797) dalam Keramba Jaring Apung dengan Sistem Polikultur. E-Journal Budidaya Perairan. 3(1).
Ramadhan, Nevita Sari., Roslaili Rasyid dan Elmatris Sy. 2015. Daya Hambat Ekstrak Daun Pegagan (Cantella asiatica) yang diambil di Batusangkar Terhadap Pertumbuhan Kuman Vibrio cholerae Secara in Vitro.Jurnal Kesehatan Andalas. 4(1).
Roihanah, S., Sukoso dan Andayani S. 2012. Aktivitas Antibakteri Ekstrak Teripang Holothuria sp. Terhadap Bakteri Vibrio harveyii Secara in Vitro. Journal Exp. Life Scienties. 2(1).
Syafutri, Merynda Indriyani., Eka Lidiasari, dan hendra Indrawan. 2010. Karakteriristik Permen Jelly Timun Suri (Cucumis melo L.) dengan Penambahan Surbitol dan Esktrak Kunyit (Curcuma domestica Val.). Jurnal Gizi dan Pangan. 5(2) : 78-86.
Trianto, Agus., Edi Wibowo, Suryono dan Rahayu Sapta S. 2004. Ekstrak Daun Mangrove Aegiceras corniculatum Sebagai Antibakteri Vibrio harveyii dan Vibrio parahaemolyticus. Jurnal Ilmu Kelautan. 9(4) : 186-189.
57
Discussion and feedback